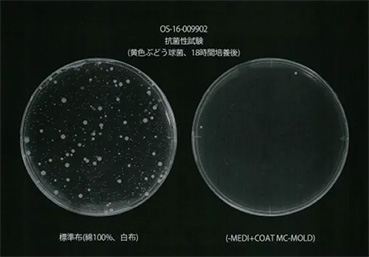
最新テクノロジーの特許取得技術
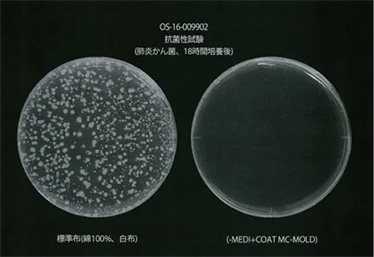
最新テクノロジーの特許取得技術

国際的に認められた
ナノテクノロジーコーティングにより、
不特定多数の人が集まる場所の
ウイルス感染リスクを軽減します。
除菌などの作業負担を軽減し、
化学物質の使用量を最小限にとどめ、
環境負荷を抑えながら感染対策ができます。
メディカルナノコート認定施工代理店

木村建設は、抗ウイルスコーティングの
パイオニア企業である、
「ナスクナノテクノロジー株式会社・
ナスクインターナショナル株式会社」の
認定施工代理店パートナー
(特約地域独占施工代理店)です。
メディカルナノコートとは
ウイルス・殺菌を
99%
不活性化新型コロナウイルス
不活性化
実証済み効果持続の目安
約3年

メディカルナノコートとは、
最新ナノテクノロジーから生まれた
抗ウイルス・抗菌コーティングで、
2009年に世界の国際空港で初めて
感染予防対策として導入された、
実績のあるウイルス感染予防コーティング技術です。
接触感染の可能性がある箇所に
『メディカルナノコート』を塗布することにより、
ウイルス・細菌を
すばやく不活性化し、
接触感染のリスクを軽減します。
メディカルナノコートは、第三者試験により
高い安全性が確認されており、
無色透明の強固で密着性
の高い薄膜が
長期間効果を持続しますので
(効果持続の目安:約3年)作業負担を軽減し、
化学物質
の使用量を最小限にとどめ、
環境負荷を抑えながら感染対策を実行できます。

最新テクノロジーの特許取得技術

ナスクナノテクノロジー株式会社の
メディカルナノコートは、
国際連合工業開発機関【UNIDO】の【STePP】に
登録されている技術です。
導入例
導入場所
-
商業施設・飲食店
-
オフィス・会議室
-
医療施設
-
教育現場
-
交通機関
-
建築物共用部
導入箇所
-
デスク・椅子
-
スイッチ・タッチパネル
-
トイレ・洗面所
-
家具・家電
-
ドアノブ
-
手摺
施工実績
-
 公共施設
公共施設・名古屋市救急救命研修所
-
 病院
病院・医療法人宝会 七宝病院
・野崎クリニック産婦人科 小児科
・名古屋掖済会病院
・まつかげシニアホスピタル -
 介護施設
介護施設・グループホーム七宝
・老人保護施設七宝園
・介護老人保健施設セーヌ蟹江
・在宅型有料老人ホームエトワール下田
・グループホームシャルル -
 学校教育
学校教育・愛知産業大学工業高等専門学校
・専修学校東洋調理技術学院 幼稚園 保育園
・たかばた保育園 -
 飲食店舗
飲食店舗・韓国料理店イモネ
・料亭松楓閣
・名古屋高島屋フードコート -
 法人・会社
法人・会社・名古屋銀行八熊支店
・SMBC日興証券㈱名古屋駅前支店
・あすなろ法律事務所
・浅賀法律事務所
・朝日珪砂鉱業株式会社
・ベントレー名古屋店
・名古屋港開発㈱ボートピア名古屋
・サン ベルグラビアゴルフクラブ
・名古屋銀行鳴尾支店 -
 ホテル
ホテル・長島観光ホテルオリーブ
-
 神社・寺院
神社・寺院・浄福寺


検証済の効果と安全性
第三者機関試験で確かな効果を検証済みです。
-
国際空港にて効果持続検証試験

拭取り検査
国際空港でコーティング施工後16ヶ月と28か月後の
細菌ふき取り検査を行い、
実空間での抗菌効果が確認され、
その成果が国際学会(国際微生物学連合2011)で
発表されています。 -
抗菌試験 一般財団法人カケンテストセンター
光のない環境下で様々な細菌やウイルスに対して抗菌効果が認められました。
-
黄色ぶとう球菌
-
肺炎かん菌
-

大腸菌
-
-
新型インフルエンザ不活性化試験/株式会社食環境研究所
【試験方法】液剤1mlに、ウイルス液を0.1ml滴下し所定時間感作させ、液剤を回収し細胞に接種して、細胞変性の有無からウイルス力価を算出する。
【結果】H1N1ウイルス(新型インフルエンザウイルス)減少率(初期値との比較)15秒で99.9% -
バクテリアフォージを用いた抗ウイルス性能評価試験/地方独立行政法人神奈川県立産業技術総合研究所
【試験方法】JIS R1756:2020(ISO 18071:2016)準用
【結果】メディカルナノコートを塗布したガラス板の抗ウイルス性能は可視光500lux4時間でウイルス減少率99.9% -
効果持続確認試験(関西国際空港で実施)/静岡県立大学環境微生物学研究所
【試験方法】 細菌ふき取り検査・食品衛試験準用
【結果】(施工カートと未施工カートとの比較)コーティング済カート48台のハンドルの平均細菌数が1個であるのに対して、未施工カートでは141個であった。
16ヶ月後、28か月後ともに同等に結果であり、微生物への効果が持続していることを確認した。 -
閉鎖パッチテスト/株式会社SOUKEN
【試験方法】「化粧品・医薬部外品製造販売ガイドブック2008」医薬部外品の承認と許可/
ヒトパッチ検査法に準拠
【結果】剥離後60分、剥離後24時間後に22名(全員)が陰性であった。
また、皮膚刺激指数は0であったことから、すべての試験品の安全性が確認された。 -
効果の確認
・新型コロナウイルス不活性化効果試験
(JIS R1756:2020およびISO18071:2016準用、公立大学法人奈良県立医科大学)
・抗菌性能試験(大腸菌、黄色ブドウ球菌、肺炎かん菌、
レジオネラ菌:JIS L1902およびISO20743準用、一般社団法人カケンテストセンター) -
安全性の確認
・皮膚一時刺激性試験(OECD Guideline for Testing of Chemicals404(2015)に準拠/
一般財団法人日本食品分析センター)
・急性経口毒性試験(OECD Guideline for Testing of Chemicals420(2001)に準拠/
一般財団法人日本食品分析センター)
・目刺激性試験(OECD Guideline for Testing of Chemicals405(2017)に準拠/
一般財団法人日本食品分析センター)
・食品衛生法おもちゃ製造基準(Ⅰ.食品衛生法・食品、添加物等の規格基準
第4おもちゃBおもちゃの製造基準に準拠/Ⅱ.食品衛生法・食品、添加物等の規格基準、
おもちゃ又は その原材料の規格に準拠、一般財団法人科学研究評価機構
高分子試験・評価センター)


